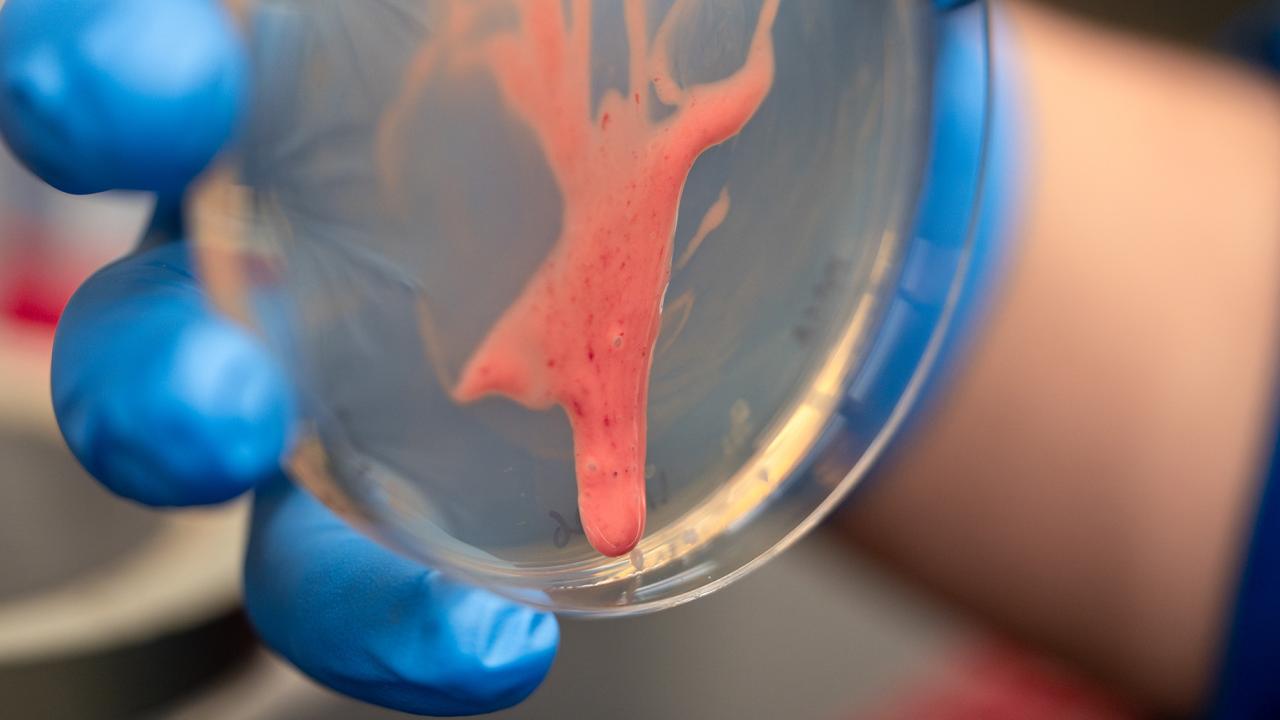
Close up of a circular plastic dish held by a hand in blue gloves. A pink gel runs down the dish.

Slippery, drippy goop makes Ralstonia bacteria devastating killers of plants, causing rapid wilting in tomato, potato and a wide range of other crops, according to new research. The work, published Jan. 22 in Proceedings of the National Academy of Sciences, comes from an unusual collaboration between plant pathologists and engineers at the University of California, Davis.
Ralstonia solanacearum can lurk in damp soils for years before infecting a plant, spreading rapidly through the water-carrying vessels (xylem). Infected plants wilt and die within days.
“My analogy is that they cause a heart attack for plants, because they clog up the vessels and cause plants to wilt and die,” said Tiffany Lowe-Power, associate professor of plant pathology in the UC Davis College of Agricultural and Environmental Sciences.
Like many bacteria, Ralstonia colonies can secrete a film or coat around themselves. Typically, these films help trap or conserve moisture. In the case of Ralstonia, this secreted film is unusually sloppy and can make them quite difficult to work with, Lowe-Power said.
“Ralstonia are charismatically disgusting, there's this like, real grossness to them,” she said.
Ralstonia’s secreted film is made up of a long, sugar-like molecule called exo polysaccharide 1 (EPS-1). It has been known that EPS-1 is somehow tied to Ralstonia’s ability to kill plants. But how?
“With the ways that microbiologists and geneticists go about answering questions, we are able to get somewhat close, but not really to the mechanism,” Lowe-Power said. “We need a physicist.”
Hari Manikantan, associate professor in the UC Davis Department of Chemical Engineering, studies the mechanics and dynamics of complex multiphase fluids.
“I love goop of all forms — saliva, foams, lung surfactants, tears,” Manikantan said.
Goopy fluids are both viscous and elastic in different degrees. Elasticity measures whether a material can snap back after being stretched. Viscosity measures how easily it flows.
Silly putty, for example, is elastic over a short time scale.
“You bounce it, it’s a perfectly solid object. If you keep it on a table, it slowly flows out over minutes to hours,” Manikantan said. “The question is what's the relevant time scale.”
A mutual love of goop
Manikantan and Lowe-Power discovered their mutual love of goop when they met during a new faculty training before the pandemic. Using equipment in Manikantan’s laboratory, they were able to make highly precise measurements of the viscoelastic properties of secretions collected from Ralstonia colonies by Matthew Cope-Arguello, a graduate student in Lowe-Power’s lab.
They discovered that the goop from pathogenic Ralstonia flows easily under the kind of shear forces that would be found in the xylem vessels of plants. This allows the bacteria to spread rapidly throughout an infected plant.
How common is this trait? Cope-Arguello developed a simple test. If you grow bacteria making a biofilm on a plate and hold the plate at an angle, does it drip? They looked at other Ralstonia strains, including those that don’t make EPS-1, and also asked colleagues around the country to test other bacteria that are evolutionary cousins of the Ralstonia wilt pathogens.
“We were really able to show, both from the data that our collaborators collected as well as data that we mined through publicly available genomes, that this polysaccharide is unique to the plant pathogens,” Cope-Arguello said.
For biologists, the research shows why EPS-1 makes these bacteria especially pathogenic. For engineers and soft matter physicists, it provides an experimental system to study.
“Now we have this actual relevant change that's guided by genetics that my community can begin to mathematically model. So I'm very excited about how this feeds back into that soft matter physics world,” Manikantan said.
Additional co-authors are: Jiayu Li, Nathali Aoun, Tabitha Cowell and Samantha Wong at UC Davis; Zachary Konkel and Jonathan Jacobs, The Ohio State University; Nicholas Wagner and Tuan Tran, University of South Alabama; A. Lin Han Chan and Kristen DeAngelis, University of Massachusetts, Amherst; Lan Thanh Chu and Loan Bui, University of Dayton, Ohio; Mariama Carter and Caitlyn Allen, University of Wisconsin-Madison; Lindsay Caverly, University of Michigan Medical School; Matthew Wargo, University of Vermont.
The work was supported in part by grants from the Academic Senate at UC Davis, the U.S. Department of Agriculture and the National Science Foundation.
Media Resources
Media Contacts
- Tiffany Lowe-Power, Plant Pathology, tlowepower@ucdavis.edu
- Harishankar Manikantan, Chemical Engineering, hmanikantan@ucdavis.edu
- Andy Fell, News and Media Relations, 530-304-8888, ahfell@ucdavis.edu